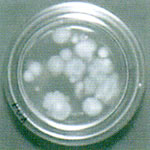
�f�b�L�u���V�Ȃǂ̏]�����@

|
トップページ>>厨房専門メンテナンス>>アワシャーシステム>>アワシャーシステムの9つのメリット

床面無人洗浄システム『アワシャー・システム』
アワシャー・システムの9つのメリット
- 1.汚染拡散の防止
- 厨房内から店内やバックヤードへ持ち出される汚染拡散の原因となる油汚れの持ち出しを防ぎます。
店内やバックヤードに持ち出される油汚れの一般的な例
- 2.臭気の低減
- アワシャーは人手による清掃では困難な機械や什器下部でも清掃可能になるため、臭気を大幅に軽減すると共に毎日洗浄することで、グリストラップにヘドロが溜まらず湧き上がる嫌なニオイも無くなります。
 |
|
 |
アワシャー設置前 |
|
アワシャー設置後 |
- 3.細菌繁殖の抑制
- 床面の有機物が洗浄されるため、落下細菌の培地が無くなり細菌の繁殖を抑制します。
|
|
 |
| デッキブラシなどの従来方法 |
|
アワシャーによる洗浄後 |
- 4.コストダウン
- 「人件費」・・・人手に頼る清掃をワンタッチで発泡→放置→洗浄の順で自動洗浄するため、デッキブラシ等を使用する人的作業の削減が可能となります。
「水道代」・・・洗浄時に使用される水は定量となるため、水道の無駄遣いが無くなります。
「洗浄量」・・・使用する洗剤は100倍から150倍に薄め、更にエアで20倍に膨張させて使うため、洗剤の使用量もグッと削減されます。
※人件費はもとより。水道代や洗剤代が大幅に節約できます。

- 5.転倒事故防止
- 床面に油分が存在すると摩擦抵抗が小さくなるため、足下が滑り易くなりますが、アワシャーを稼働させることにより、専用洗剤アワフルLが床面の油汚れを除去し、すべり難くします。
- 6.ゴキブリの忌避
- 洗浄により、エサとなる有機物が取り除かれ床面のゴキブリを忌避する環境をつくります。また、床面からゴキブリがいなくなるのは、仲間へ危険フェロモンを発するため他のゴキブリも寄りつかなくなるのでは?と考えられています。
- 7.モラル向上
- 床を泡で覆うことから直置き(トレイetc.)が出来なくなり、物を収納する習慣がつきます。
- 8.疲労改善
- 滑りやすい床面で作業をすると、つま先にどうしても力が入ることから疲れやすくなります。床面が滑り難くなるため疲労が改善されます。
- 9.常時清掃可能
- 機械による自動洗浄は、仕事中もゴム靴を着用していれば作業を中断せず洗浄が出来ます。泡は水のように跳ね上がらないため、滑ることもなく1日に何回でも洗浄ができます。(生産作業中は、ドライ環境で作業してください。)
トップページ>>厨房専門メンテナンス>>アワシャーシステム>>アワシャーシステムの9つのメリット
|